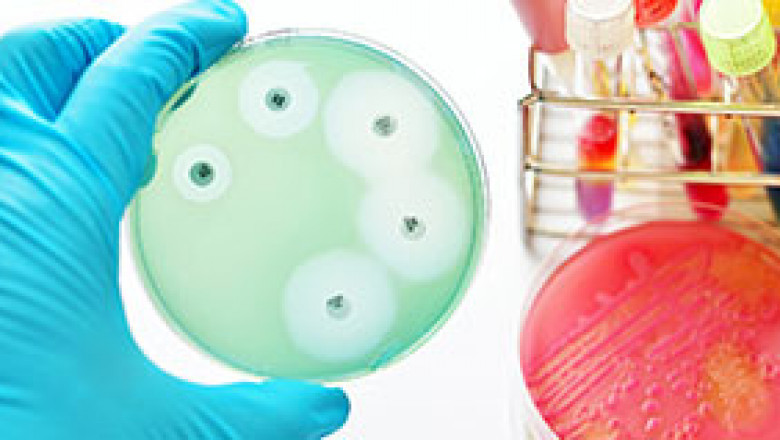

views
According to the new market research report Antimicrobial Susceptibility Testing Market Trends by Product (Manual, Automated Susceptibility Testing System), Type (Antibacterial, Antifungal), Application (Clinical Diagnostics), Method (ETEST, Disk Diffusion), End-User - Global Forecasts to 2025, published by MarketsandMarkets™, the Antimicrobial Susceptibility Testing Market is projected to reach USD 4.2 billion by 2025 from USD 3.2 billion in 2020, at a CAGR of 5.5% during the forecast period.
Download PDF Brochure: https://www.marketsandmarkets.com/pdfdownloadNew.asp?id=206359984
Growth in this market is primarily driven by the rising incidence of infectious diseases; technological advancements towards the development of rapid AST technologies; increased funding, research grants, and public-private investments; growing government initiatives to detect and control antimicrobial-resistant species; and the emergence of multidrug resistance due to drug abuse.
Opportunity: Awareness initiatives for antimicrobial resistance and its control
Antimicrobial susceptibility tests play a significant role in detecting the resistance of bacteria to antibiotics. Healthcare authorities are increasingly becoming aware of the significance of antimicrobial susceptibility to ensure the efficacy and safety of AST methods. Various initiatives—for instance, the Global Sepsis Alliance (GSA), a non-profit organization located in the US, works to support over one million caregivers in more than 70 countries and increase awareness about sepsis and its management. Likewise, in the US, the CDC launched a new website, Antibiotic / Antimicrobial Resistance (AR / AMR), to increase AMR awareness and support the early recognition, diagnosis, and treatment of antibiotic resistance. Along with this, various local government and intergovernmental organizations such as the WHO, EU, Transatlantic Task Force on Antimicrobial Resistance (TATFAR), and Global Health Security Agenda (GHSA) are developing and implementing plans and efforts to tackle antimicrobial resistance.
Based on application, the antimicrobial susceptibility testing market share has been segmented into the market is segmented into clinical diagnostics, drug discovery and development, epidemiology, and other applications. Significant market growth in the clinical diagnostics segment can be attributed to the rising burden of infectious diseases, the growing burden of antimicrobial resistance, and new product launches in the market.
Based on the product, the antimicrobial susceptibility testing market is segmented into automated laboratory instruments, manual antimicrobial susceptibility testing products, culture and growth media, and consumables. The manual susceptibility testing products segment is further divided into susceptibility testing disks, MIC strips, and susceptibility testing plates. Among the manual antimicrobial susceptibility testing products, the susceptibility testing disks segment held a major share of the market in 2019. The high quality, low cost, and ease of use of these products are increasing the adoption of susceptibility testing disks in emerging countries. Some prominent players offering susceptibility testing disks include BD (US), Thermo Fisher Scientific, Inc. (US), Bio-Rad Laboratories, Inc. (US), and HiMedia Laboratories (India).
North America, comprising the US and Canada, accounted for the largest share of the antimicrobial susceptibility testing market size in 2019. Technological advancements in rapid antimicrobial susceptibility testing systems, rising incidence of infectious diseases (such as AIDS, tuberculosis, and pertussis), and government support for antimicrobial resistance-related research are the major factors driving market growth in North America. As AST through conventional methods is a lengthy process, customers in North America are moving towards rapid AST techniques, which require minimal reagents. This trend will have a positive impact on the automated instruments market.
Request For Free Report Sample: https://www.marketsandmarkets.com/requestsampleNew.asp?id=206359984
bioMérieux SA (France), Becton, Dickinson and Company (US), Thermo Fisher Scientific (US), Danaher Corporation (US), Bio-Rad Laboratories, Inc. (US), Bruker (US), Roche Diagnostics Limited (Switzerland), Accelerate Diagnostics, Inc. (US), Merck KGaA (US), Hi-Media Laboratories (India), Liofilchem S.r.l. (Italy), Alifax S.r.l. (Italy), Creative Diagnostics (US), Synbiosis (UK), Bioanalyse (Turkey), ZHUHAI DL BIOTECH Co., Ltd. (China), ELITechGroup (France), Mast Group Ltd. (UK), CONDALAB (Spain), Genefluidics, Inc. (US), Biotron Ltd (Australia), InvivoGen (US), MP Biomedicals (US), QuantaMatrix Inc. (South Korea), and PML Microbiologicals Inc. (US), among others are some of the major players operating in the global AST market.
Contact:
Mr. Aashish Mehra
MarketsandMarkets™ INC.
630 Dundee Road
Suite 430
Northbrook, IL 60062
USA: +1-888-600-6441
Email: sales@marketsandmarkets.com
Related Reports:
https://www.marketsandmarkets.com/Market-Reports/microbiology-testing-market-219135367.html
https://www.marketsandmarkets.com/Market-Reports/sepsis-diagnostic-market-92673155.html